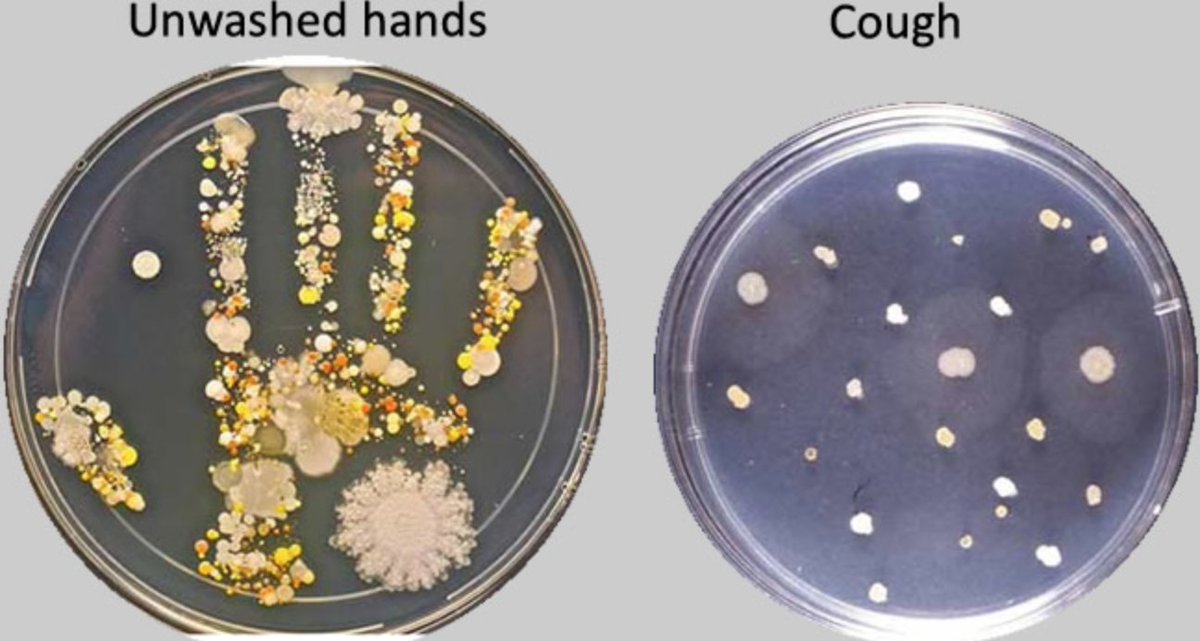
Maurizio Cecconi Icu Anaesthesia On Twitter No This Is Not Sarscov2 As It Would Not Grow On This But This Picture Shows Why Washing Hands And Wearing Facemasks Can Be
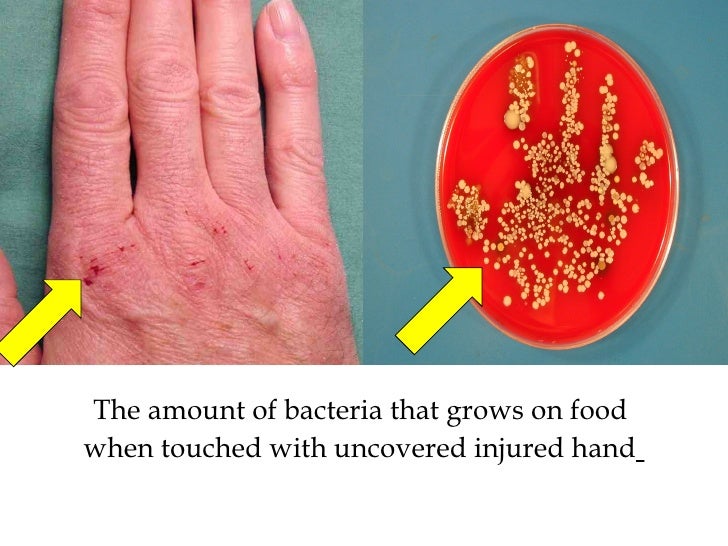
Rh 3 Hand Hygiene
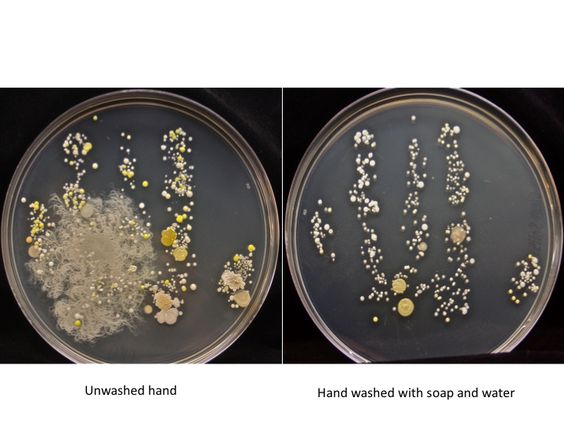
Everything Micro

Unwashed hands bacteria
Unwashed Hands Bacteria. Swabs were taken from a randomly selected sample of 60 medical students for bacterial count from both hands before and after toilet use and from door knobs of six toilets. Their hands were then tested for the presence of bacteria. Humans on the other hand were carrying higher levels of bacteria overall and nearly a quarter of the 234 people tested had dangerous levels of these germs. Soap and water can outperform expensive antibacterial products as long as adequate time is spent washing your hands.

Their hands were then tested for the presence of bacteria. The physical action of washing our hands by rubbing them together is the best way to get rid of them. We trained a microscope on the bacteria living on things that we touch without a second thought. Put simply your hands are dirty. Daily mail online used glo germ lotion that revealed the. Humans on the other hand were carrying higher levels of bacteria overall and nearly a quarter of the 234 people tested had dangerous levels of these germs.
Only 40 66 7 claimed they washed hands with soap.
Their hands were then tested for the presence of bacteria. We take the glo germ test to show what works and what doesn t to banish bacteria this flu season. Does hand washing remove bacteria. Swabs were taken from a randomly selected sample of 60 medical students for bacterial count from both hands before and after toilet use and from door knobs of six toilets. Soap and water can outperform expensive antibacterial products as long as adequate time is spent washing your hands. Their hands were then tested for the presence of bacteria.
 Source: today.com
Source: today.com
The physical action of washing our hands by rubbing them together is the best way to get rid of them. The physical action of washing our hands by rubbing them together is the best way to get rid of them. Does hand washing remove bacteria. Coli often blamed for food poisoning. Researchers at the london school of hygiene and tropical medicine tested whether hand washing with plain water or with soap and water could destroy bacteria that came from feces.
 Source: independent.co.uk
Source: independent.co.uk
We trained a microscope on the bacteria living on things that we touch without a second thought. As they come into contact with various people animals foods and surfaces they pick up thousands of germs bacteria viruses and other assorted nastiness that. Put simply your hands are dirty. So the best way to clean our hands of bacteria is not so much what we use but the way we use it. In fact dirty surfaces had relatively low levels of dangerous bacteria including the e.
 Source: wfyi.org
Source: wfyi.org
The physical action of washing our hands by rubbing them together is the best way to get rid of them. Significantly more females 83 used soap to wash hands compared to males 50. Coli often blamed for food poisoning. Researchers at the london school of hygiene and tropical medicine tested whether hand washing with plain water or with soap and water could destroy bacteria that came from feces. Swabs were taken from a randomly selected sample of 60 medical students for bacterial count from both hands before and after toilet use and from door knobs of six toilets.

Soap and water can outperform expensive antibacterial products as long as adequate time is spent washing your hands. We take the glo germ test to show what works and what doesn t to banish bacteria this flu season. Volunteers touched door handles and railings in public places. Researchers at the london school of hygiene and tropical medicine tested whether hand washing with plain water or with soap and water could destroy bacteria that came from feces. Humans on the other hand were carrying higher levels of bacteria overall and nearly a quarter of the 234 people tested had dangerous levels of these germs.
 Source: livewellmagazine.org
Source: livewellmagazine.org
And let s just say that since then we haven t used the cu. Their hands were then tested for the presence of bacteria. Does hand washing remove bacteria. Swabs were taken from a randomly selected sample of 60 medical students for bacterial count from both hands before and after toilet use and from door knobs of six toilets. Researchers at the london school of hygiene and tropical medicine tested whether hand washing with plain water or with soap and water could destroy bacteria that came from feces.
 Source: prnewswire.com
Source: prnewswire.com
The physical action of washing our hands by rubbing them together is the best way to get rid of them. Humans on the other hand were carrying higher levels of bacteria overall and nearly a quarter of the 234 people tested had dangerous levels of these germs. Put simply your hands are dirty. In fact dirty surfaces had relatively low levels of dangerous bacteria including the e. We take the glo germ test to show what works and what doesn t to banish bacteria this flu season.
Source: twitter.com
Source: twitter.com
As they come into contact with various people animals foods and surfaces they pick up thousands of germs bacteria viruses and other assorted nastiness that. And let s just say that since then we haven t used the cu. Put simply your hands are dirty. Their hands were then tested for the presence of bacteria. Humans on the other hand were carrying higher levels of bacteria overall and nearly a quarter of the 234 people tested had dangerous levels of these germs.
Source: slideshare.net
Source: slideshare.net
Researchers at the london school of hygiene and tropical medicine tested whether hand washing with plain water or with soap and water could destroy bacteria that came from feces. We take the glo germ test to show what works and what doesn t to banish bacteria this flu season. Daily mail online used glo germ lotion that revealed the. Do you know how dirty your hands are. Bacteria from an unwashed hand left and the same hand after it had been washed with soap and water.

Significantly more females 83 used soap to wash hands compared to males 50. Soap and water can outperform expensive antibacterial products as long as adequate time is spent washing your hands. Bacteria from an unwashed hand left and the same hand after it had been washed with soap and water. Only 40 66 7 claimed they washed hands with soap. Does hand washing remove bacteria.
 Source: avitahealth.org
Source: avitahealth.org
As they come into contact with various people animals foods and surfaces they pick up thousands of germs bacteria viruses and other assorted nastiness that. Significantly more females 83 used soap to wash hands compared to males 50. Coli often blamed for food poisoning. And let s just say that since then we haven t used the cu. Soap and water can outperform expensive antibacterial products as long as adequate time is spent washing your hands.
 Source: channelnewsasia.com
Source: channelnewsasia.com
As they come into contact with various people animals foods and surfaces they pick up thousands of germs bacteria viruses and other assorted nastiness that. Coli often blamed for food poisoning. Humans on the other hand were carrying higher levels of bacteria overall and nearly a quarter of the 234 people tested had dangerous levels of these germs. Researchers at the london school of hygiene and tropical medicine tested whether hand washing with plain water or with soap and water could destroy bacteria that came from feces. The physical action of washing our hands by rubbing them together is the best way to get rid of them.
 Source: youtube.com
Source: youtube.com
Soap and water can outperform expensive antibacterial products as long as adequate time is spent washing your hands. We take the glo germ test to show what works and what doesn t to banish bacteria this flu season. Swabs were taken from a randomly selected sample of 60 medical students for bacterial count from both hands before and after toilet use and from door knobs of six toilets. Humans on the other hand were carrying higher levels of bacteria overall and nearly a quarter of the 234 people tested had dangerous levels of these germs. Put simply your hands are dirty.

And let s just say that since then we haven t used the cu. We take the glo germ test to show what works and what doesn t to banish bacteria this flu season. In fact dirty surfaces had relatively low levels of dangerous bacteria including the e. So the best way to clean our hands of bacteria is not so much what we use but the way we use it. The physical action of washing our hands by rubbing them together is the best way to get rid of them.
Source: everythingmicro.blogspot.com
Source: everythingmicro.blogspot.com
Researchers at the london school of hygiene and tropical medicine tested whether hand washing with plain water or with soap and water could destroy bacteria that came from feces. Only 40 66 7 claimed they washed hands with soap. Their hands were then tested for the presence of bacteria. Coli often blamed for food poisoning. Do you know how dirty your hands are.
 Source: slideshare.net
Source: slideshare.net
Only 40 66 7 claimed they washed hands with soap. Only 40 66 7 claimed they washed hands with soap. In fact dirty surfaces had relatively low levels of dangerous bacteria including the e. Put simply your hands are dirty. The physical action of washing our hands by rubbing them together is the best way to get rid of them.
If you find this site value, please support us by sharing this posts to your own social media accounts like Facebook, Instagram and so on or you can also save this blog page with the title unwashed hands bacteria by using Ctrl + D for devices a laptop with a Windows operating system or Command + D for laptops with an Apple operating system. If you use a smartphone, you can also use the drawer menu of the browser you are using. Whether it’s a Windows, Mac, iOS or Android operating system, you will still be able to bookmark this website.






